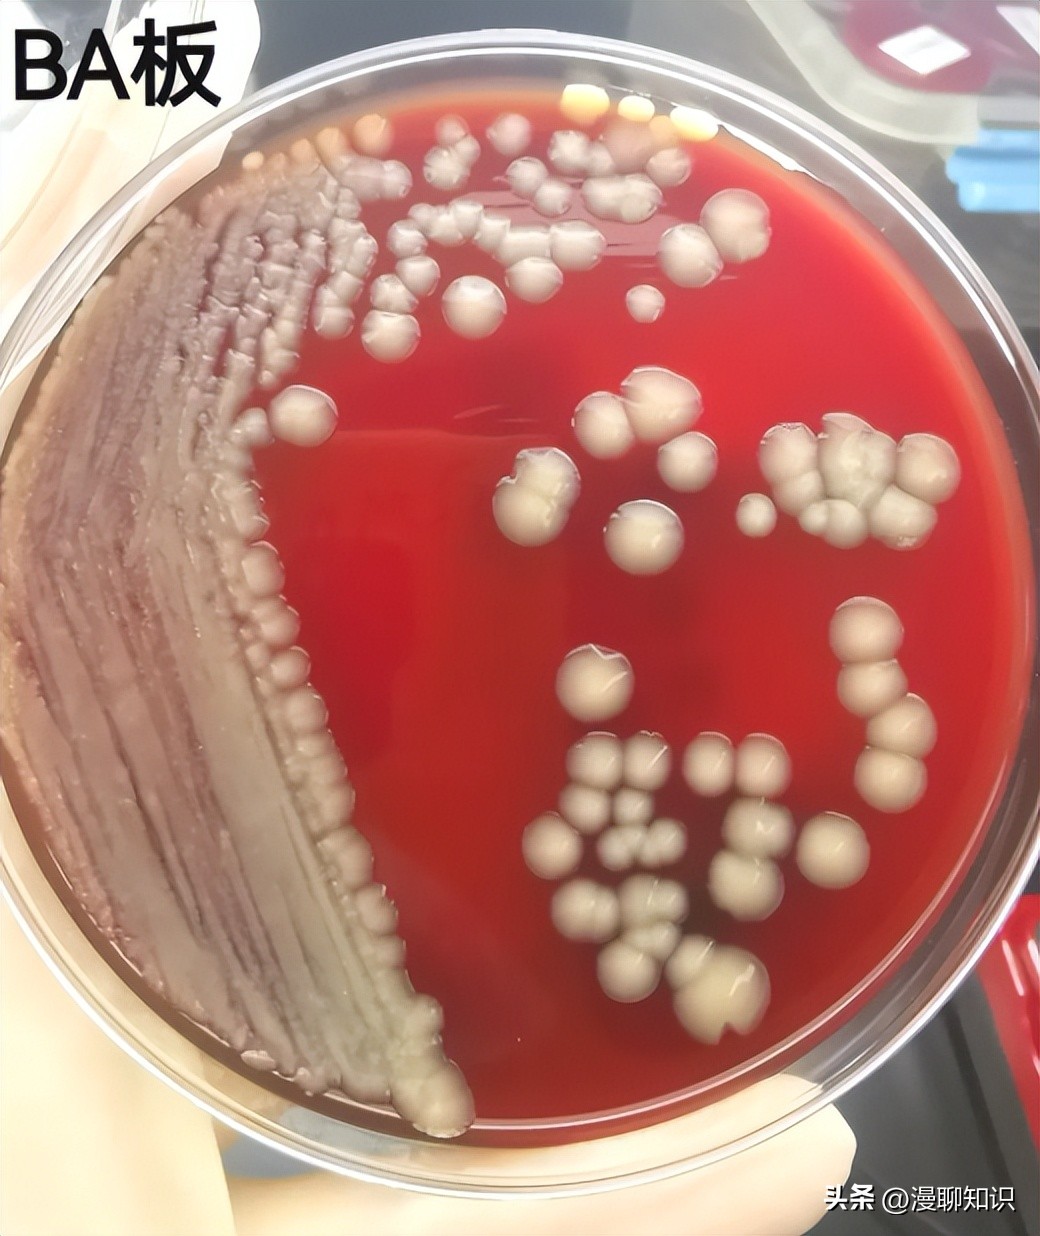
老年人得了肺炎应如何有效医治,肺炎有多严重怎么办
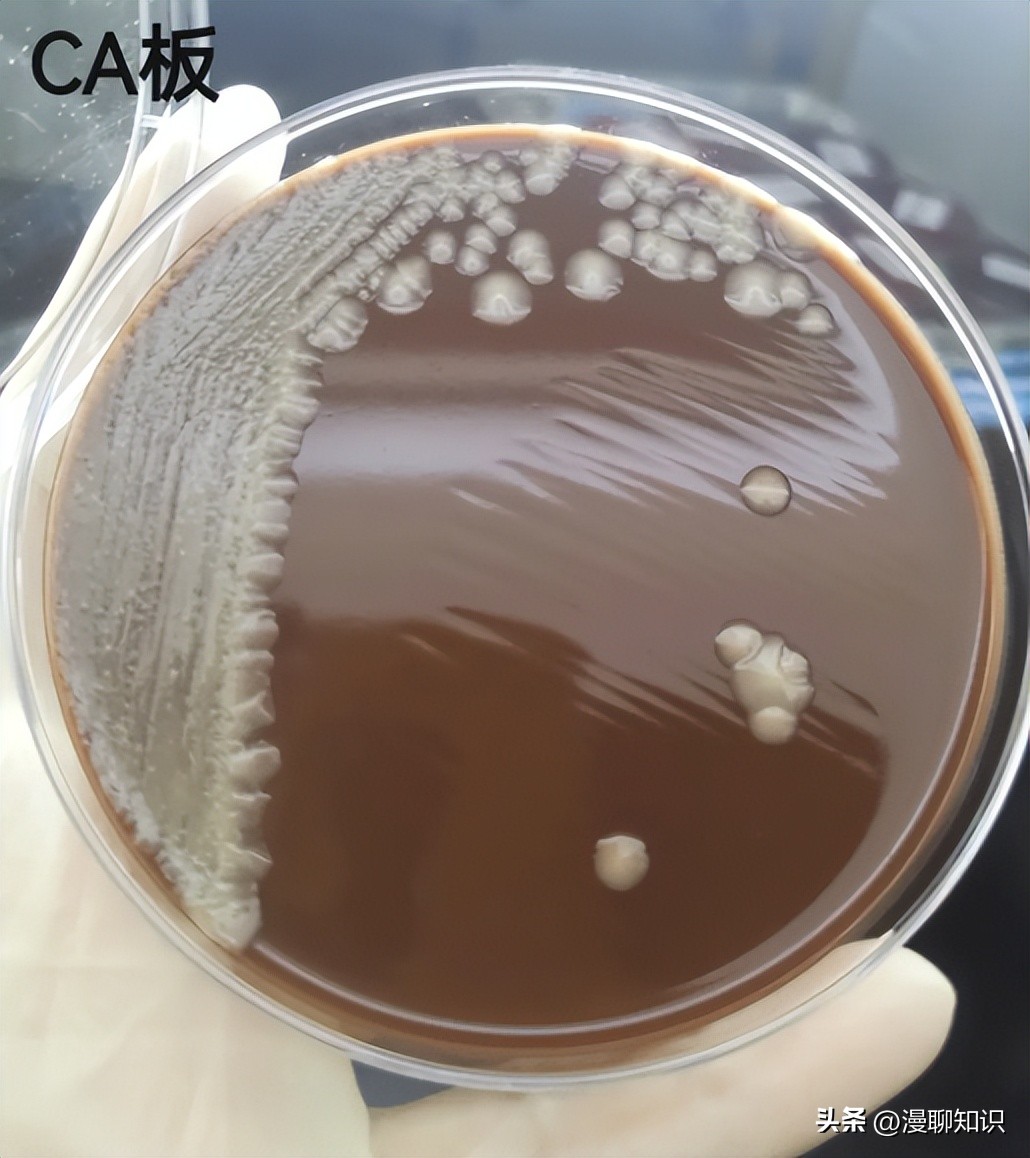
老年人得了肺炎应如何有效医治,肺炎有多严重怎么办
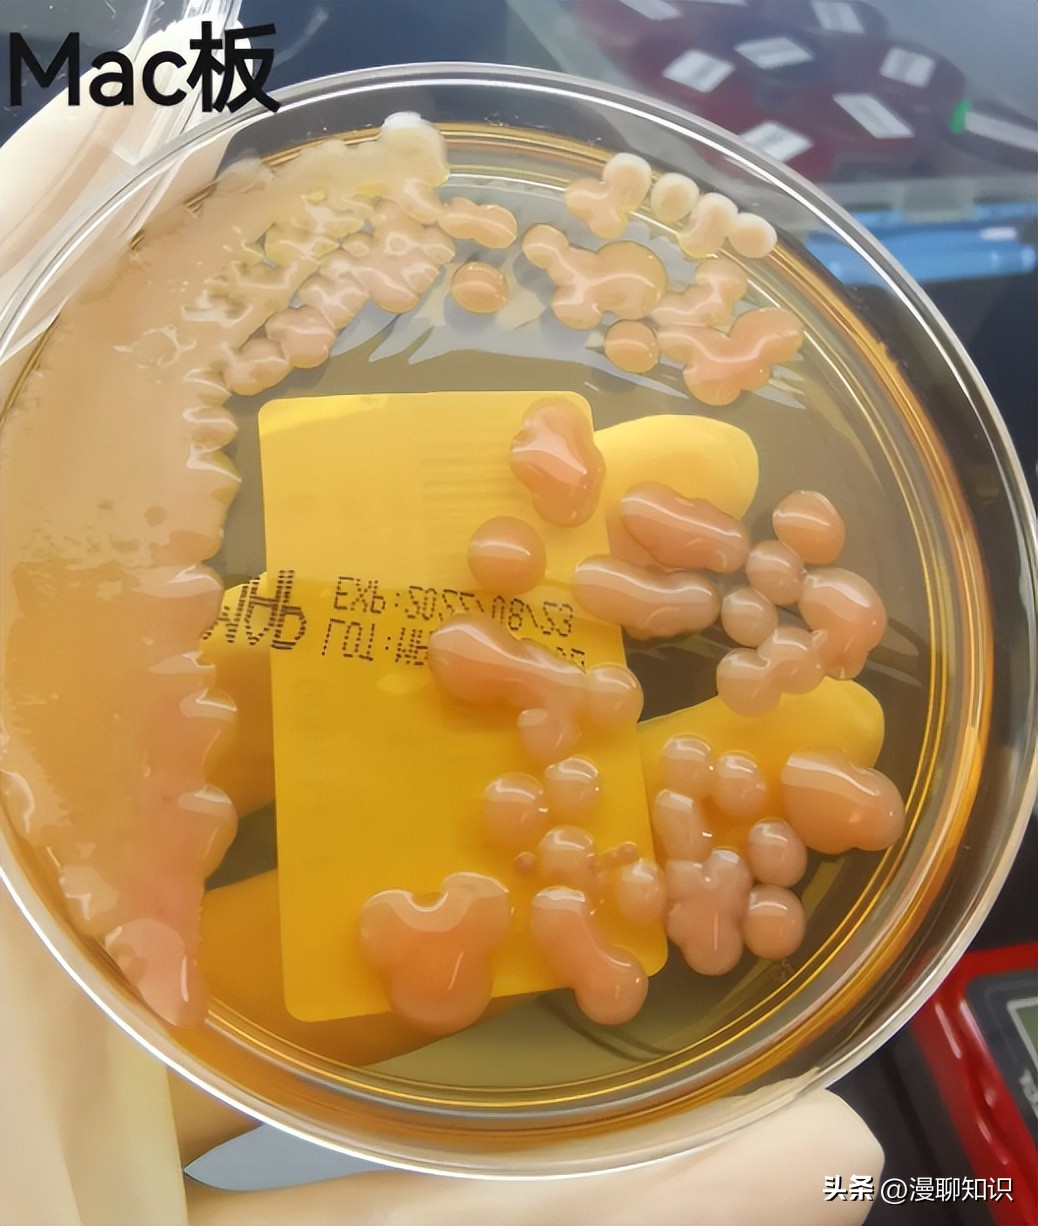
老年人得了肺炎应如何有效医治,肺炎有多严重怎么办
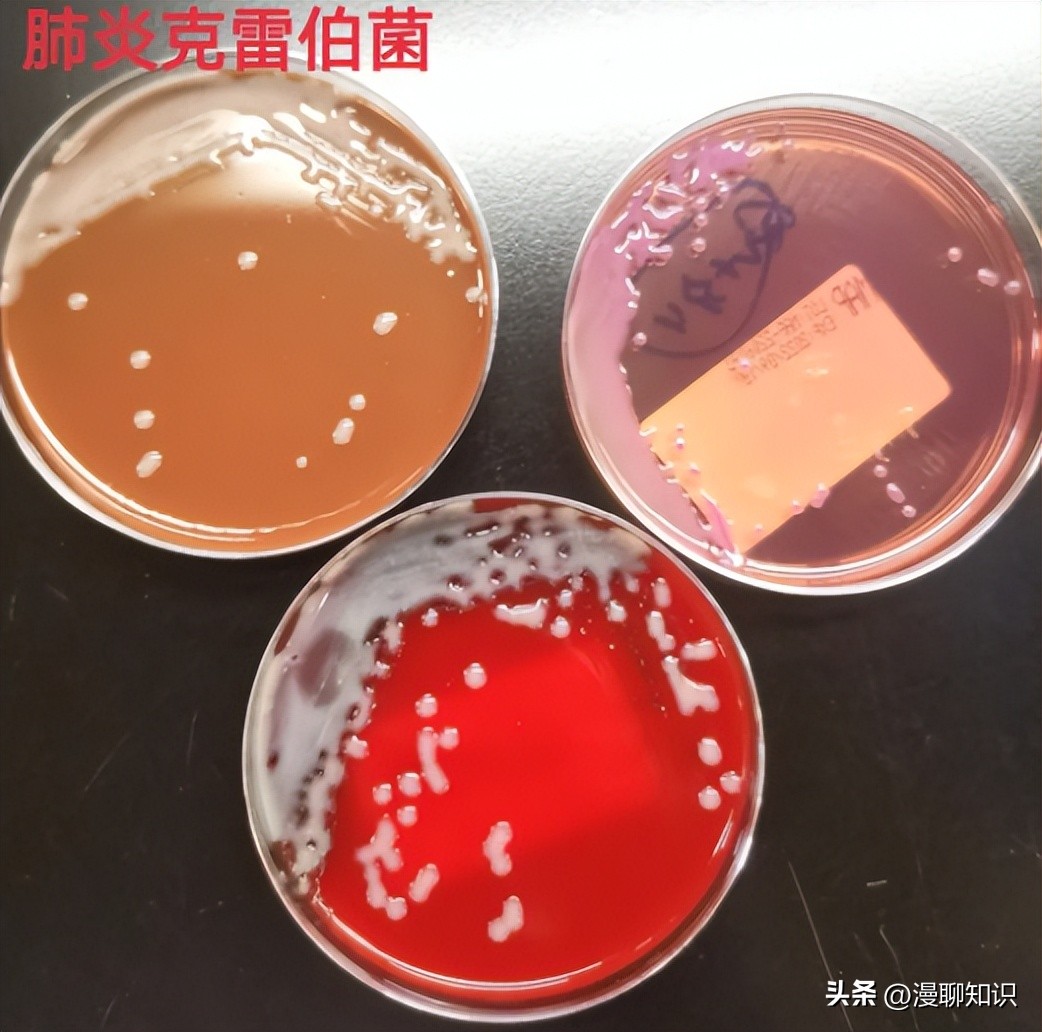
老年人得了肺炎应如何有效医治,肺炎有多严重怎么办
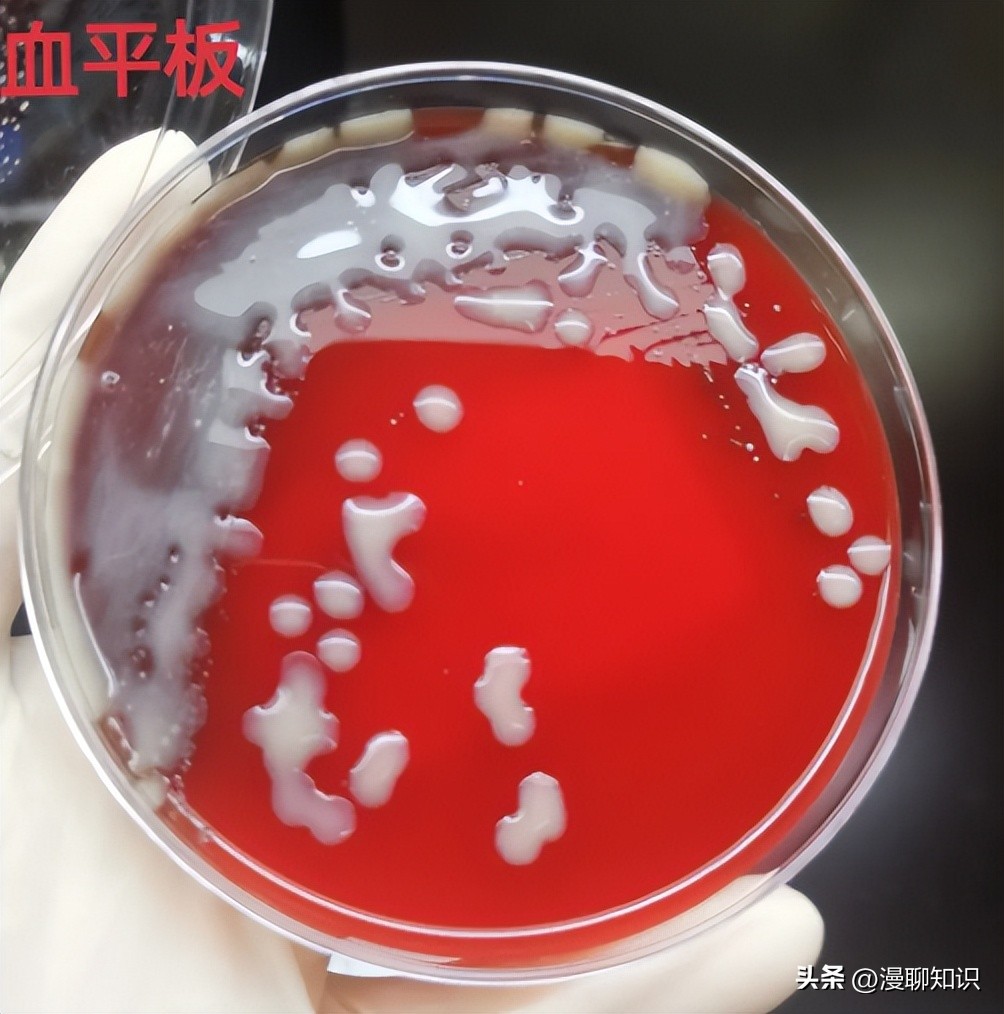
老年人得了肺炎应如何有效医治,肺炎有多严重怎么办
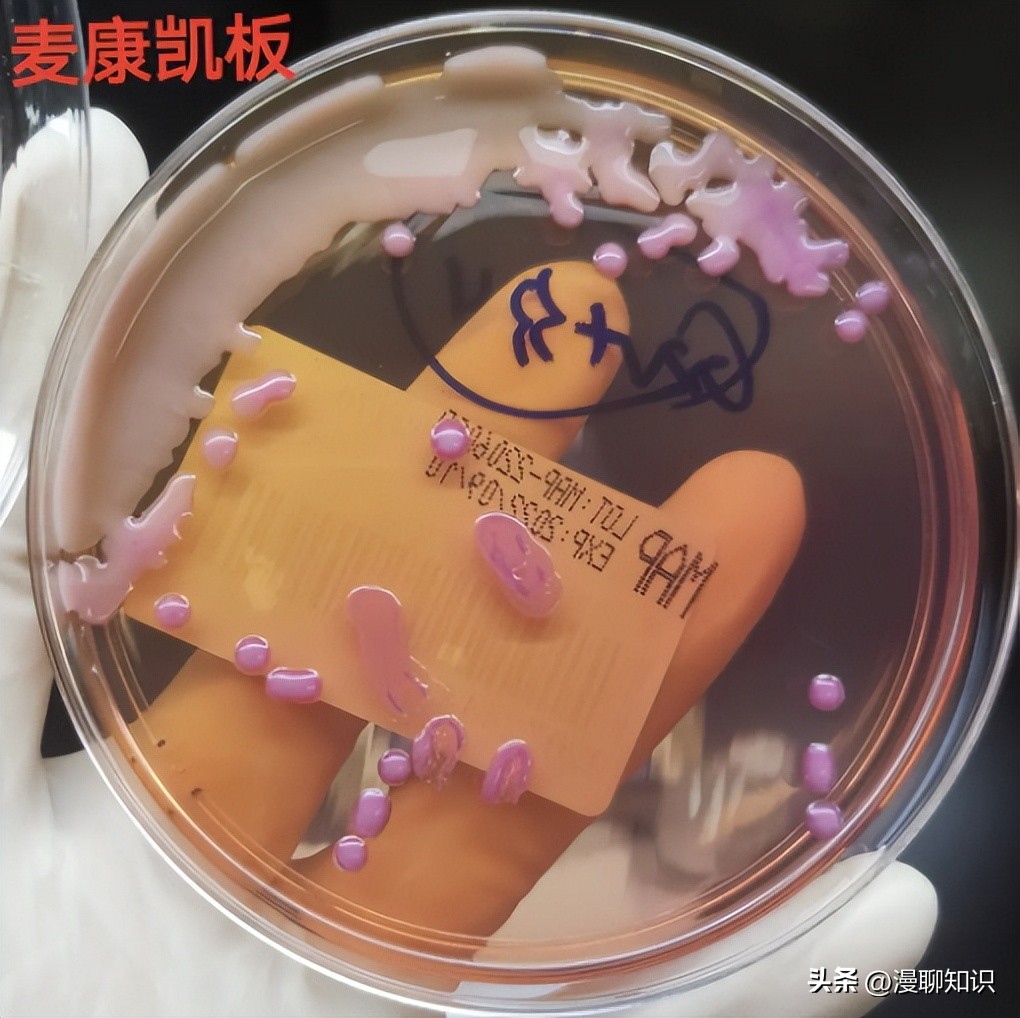
老年人得了肺炎应如何有效医治,肺炎有多严重怎么办
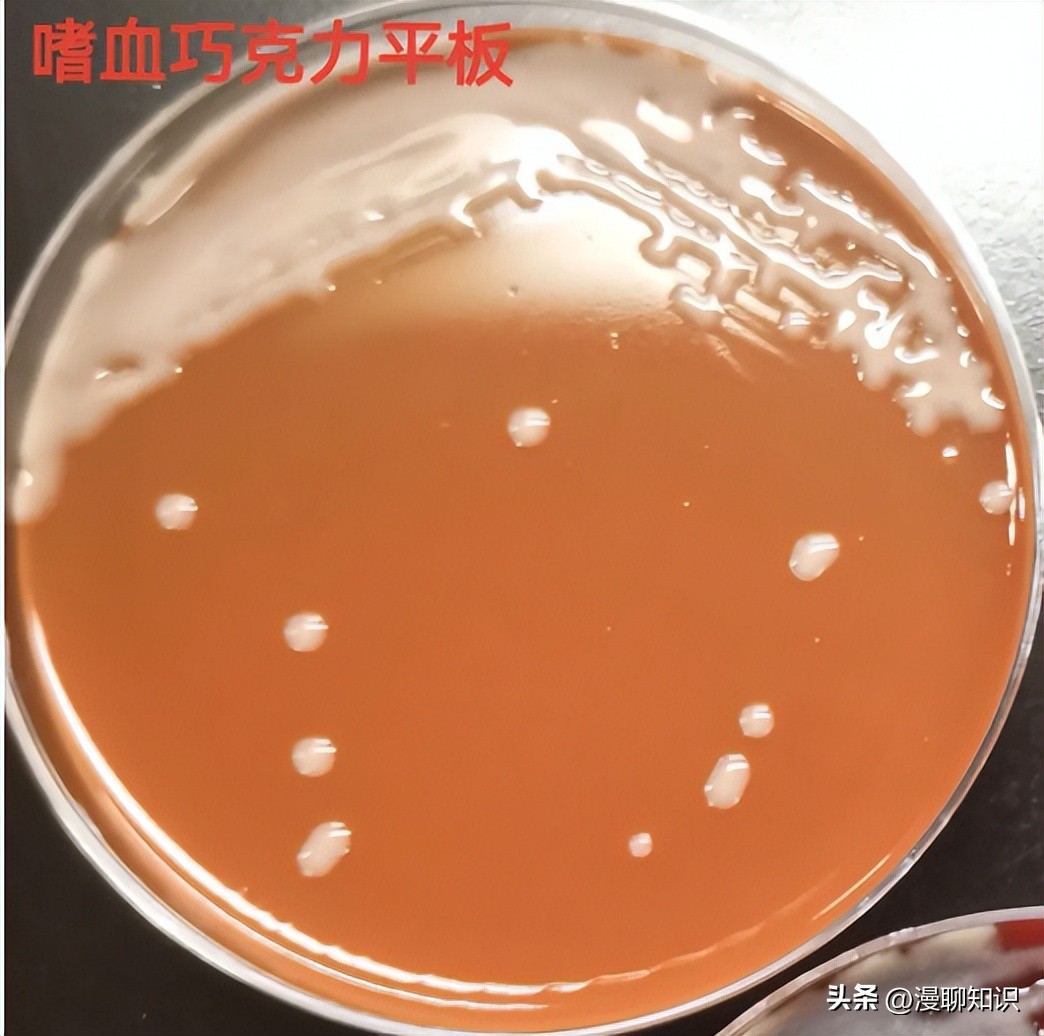
老年人得了肺炎应如何有效医治,肺炎有多严重怎么办
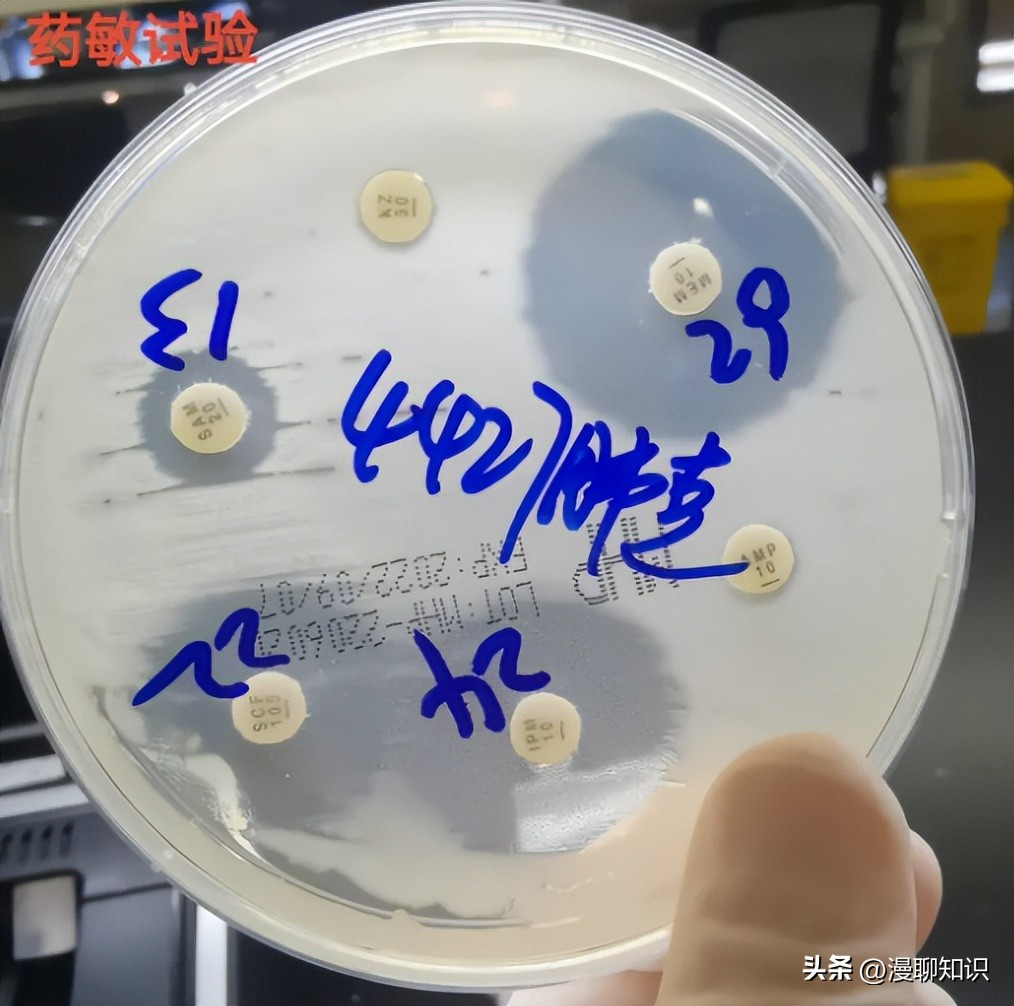
老年人得了肺炎应如何有效医治,肺炎有多严重怎么办
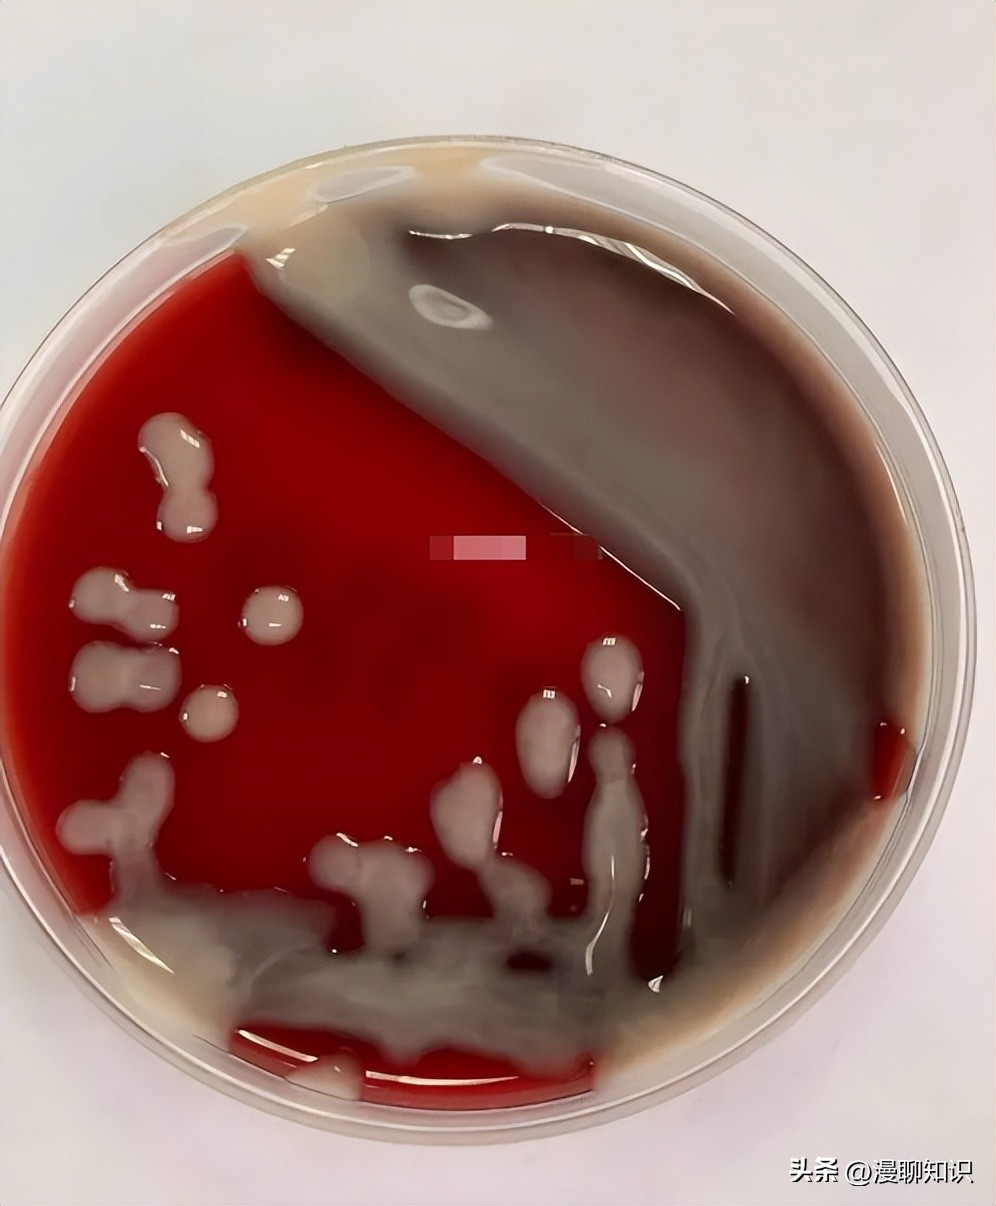
老年人得了肺炎应如何有效医治,肺炎有多严重怎么办

阅读文章前,辛苦您点下右上角的“关注”,方便您讨论分享,持续关注每日优质内容~
肺炎克雷伯菌(Klebsiella pneumoniae, Kp)属于革兰氏阴性杆菌,是一种机会性病原体,可导致免疫功能低下的个体感染,同时其也是慢性支气管炎下呼吸道感染患者中最常见的病原菌之一。
有研究表明,老年慢性支气管炎呼吸道感染患者中,主要致病的革兰氏阴性菌是肺炎克雷伯菌。
Kp感染老年患者后,引发肺部炎症、慢性支气管炎、肺气肿及慢性阻塞性肺疾病等急性发作,病情发展迅速,严重影响患者生活质量及生命健康。

芪风固表颗粒是黑龙江省中医药科学院自主研发的中成药(发明专利号:CN1325098C,批准文号:国药准字:B20020410),由黄芪、刺五加、五味子、白术、麦冬、防风六味中药组成,具有健脾、补肺、益肾、益气固表的功效,用于肺、脾、肾虚弱所致的慢性咳嗽缓解期辅助治疗。
前期研究表明,该方具有广泛的调节免疫作用,能够扶助正气,减轻慢性阻塞性肺疾病发作症状及次数,从而达到祛除病邪、预防慢性肺系疾病的目的。
本研究通过建立Kp感染BALB/C小鼠模型,以Kp感染引发的急性炎症作为切入点,发现芪风固表颗粒通过抑制Caspase-11焦亡通路减轻炎症反应作用的机制。
芪风固表颗粒由黑龙江省中医药科学院制剂室提供(批号:20191209);肺炎克雷伯菌购于中国工业微生物菌种保藏管理中心(菌种编号:CICC 10870);泛福舒购于瑞士OM Pharma SA 公司(批号:1800273)。
Real-Time PCR试剂盒购于北京康为世纪生物科技有限公司(货号:CW0659S);免疫组化试剂盒购于北京中杉金桥生物技术公司(批号:2127A0705)。
一抗(Pannexin 1、P2RX7)购于北京博奥森生物技术有限公司(货号:AH08066372、AC06134578);一抗Caspase-11购于英国Abcam公司(货号:GR3366916-3);二抗(山羊抗兔IgG/辣根酶标记)购于北京中杉金桥生物技术公司(货号:ZB-2305)。
TECAN M200多功能酶标仪(奥地利TECAN公司)、SORVALL ST 16R冷冻离心机(德国赛默飞世尔公司)、Sorvall Mircro17微量离心机(德国赛默飞世尔公司)、MEK7222K血细胞分析仪(沈阳乐雅科技有限公司)、Line Gene 9600 Real-Time PCR仪(日本大和博日公司)、BX41荧光显微镜(日本奥林巴斯公司)、CLASS Ⅱ TYPE B2型生物洁净安全柜(北京东联哈尔仪器制造有限公司)。
SPF级6周龄BALB/C小鼠60只,雄雌各半,体质量20~22 g, 购于哈尔滨医科大学,生产许可证号:SCXK(黑)2019-001。动物实验伦理审查批号:SY3R-2018034。
实验前1周自由进食进水,分笼饲养。
将肺炎克雷伯菌接种于LB琼脂平皿中,于37 ℃恒温培养箱培养20 h, 挑取单个菌落,传代培养,传至第3代后,接种于LB液体培养基中,并在37 ℃培养箱中培养20 h。
随机将BALB/C小鼠分为:芪风固表颗粒高、中、低剂量组,泛福舒胶囊组,模型组,空白组,雌雄各半,每组10只。
灌胃给药,芪风高、中、低剂量组(2.6 g/kg、1.3 g/kg、0.65 g/kg)(以人临床用量作为中剂量,人临床用量:10 g/d),泛福舒组0.63 mg/kg, 每天1次,连续灌胃给药40 d。
空白组和模型组予相同体积蒸馏水,给药结束后模型组和各给药组小鼠*醚乙**麻醉,滴鼻感染5×108CFU/mL肺炎克雷伯菌50 μL一次。

在末次滴鼻感染结束24 h后,处死小鼠,取右肺做HE染色,左肺取肺泡灌洗液(BALF);并留取部分肺组织保存于-80 ℃冰箱中进行后续实验。
小鼠右肺铺展在包埋盒中于10%甲醛中浸泡后进行包埋,切片,染色,封片。
200倍视野下观察肺组织及肺泡结构、肺出血情况、肺泡及血管壁的炎细胞浸润、肺泡壁是否增厚等病理变化并拍照。
处死小鼠后,用止血钳将右侧肺叶结扎,再用1 mL注射器插入气管上端,0.5 mL生理盐水反复冲洗3遍,收集肺泡灌洗液,血细胞分析仪分析比较各组肺泡灌洗液白细胞数。

取50 mg肺组织放入研磨管,加入1 mL无菌PBS,研磨直至无固态组织,无菌枪头吸入到1.5 mL Ep管内,10倍比稀释,LB平板滴板,37 ℃过夜,次日计各组菌落数。
肺组织石蜡切片烘干,脱蜡,孵育3%H2O2,枸橼酸缓冲液加压煮沸,一抗Pannexin1、P2RX7(1∶500)4 ℃过夜,反应增强液室温孵育,增强酶标山羊抗兔IgG聚合物室温孵育,显色,复染,反蓝,脱水、冲洗、封片,200倍视野下阅片,于显微图像软件CellSens Entry下拍照分析;使用Image-Pro Plus 6.0软件分析IOD/Area比值。
取各组小鼠肺组织50 mg, 提取总蛋白,用BCA法测定蛋白浓度后,进行SDS聚丙烯酰胺凝胶电泳,将凝胶上蛋白用湿法转移至PVDF膜上后,加入含5%脱脂奶粉的封闭液,摇床振荡反应3~4 h。
封闭结束用TBST洗膜3次。
一抗Pannexin1/P2RX7(1∶2 000稀释),Caspase-11(1∶1 000稀释),4 ℃孵育12~16 h后,加入二抗(1∶2 500稀释),室温避光摇床1 h, 使用凝胶成像仪成像,Quantity One系统进行灰度值分析。
各组小鼠肺组织加入Trizol试剂提取RNA,经酶标仪检测浓度后,将纯度在1.8~2.0的RNA用DEPC水稀释至浓度为100 ng/μL。
PCR反应体系:1 μL稀释后的小鼠肺组织RNA,1 μL上下游引物,23 μL反应液(按PCR试剂盒说明书配置:2×UltraSYBR One Step Buffer: 12.5 μL,UltraSYBR One Step EnzymeMix: 0.5 μL,RNase-Free Water: 10 μL)。
扩增条件:95 ℃ 10 min, 95 ℃ 10 s、60 ℃ 30 s、72 ℃ 30 s、40个循环;熔解曲线条件:95 ℃ 10 s, 台阶采样,台阶温度0.5 ℃。
|
分组 |
引物基因序列 |
|
Pannexin1正向 |
5′-CTACAGACCAAGGGAGAGGACCAG-3′ |
|
Pannexin1反向 |
5′-CCATTAGCAGGACGGATTCAGAAGC-3′ |
|
P2RX7正向 |
5′-CCCACAGAGCAAAGGAATCCAGAC-3′ |
|
P2RX7反向 |
5′-TAGGACACCAGGCAGAGAGACTTCAC-3′ |
|
Caspase-11正向 |
5′-GGAGCACGGTGGAAGAAGACAAC-3′ |
|
Caspase-11反向 |
5′-GTGAAGAGGAGGAGGAGTGGATGG-3′ |
|
β-actin正向 |
5′-GACGGCCAGGTCATCACTATTG-3′ |
|
β-actin反向 |
5′-AGGAAGGCTGGAAAAGAGCC-3′ |
采用SPSS 26.0软件统计数据,单因素方差分析方法分析组间差异,以*P<0.05或**P<0.01表示差异有统计学意义。
小鼠肺组织进行HE染色后,通过显微镜观察各组肺组织的病理改变。
模型组中肺组织病理改变明显,肺泡结构模糊,肺泡壁大量充血,以及大量炎细胞浸润,血管有充血,支气管病变不明显。
芪风固表高剂量组肺组织结构与空白组肺组织结构相似,与模型组相比有所改善,仅有少量充血和炎细胞浸润;芪风固表中剂量组和低剂量组与模型组对比也有所改善,肺泡壁充血有所改善,以及少量炎细胞浸润。
BALF经血细胞分析仪分析显示:模型组较空白组中白细胞明显增多(P<0.01)。
芪风固表颗粒组较模型组BALF白细胞数明显减少(P<0.05,P<0.01),芪风固表高剂量组较泛福舒组BALF白细胞数明显减少(P<0.05)。
通过菌落计数,结果显示,芪风固表颗粒高、中剂量组较模型组细菌含量数降低(P<0.05);芪风固表各剂量组与泛副舒组比较肺组织内细菌含量无明显差异。
芪风固表颗粒对肺组织细菌浓度的影响
|
分组 |
n |
菌浓度(104CFU/mL) |
|
芪风高组 |
3 |
3.10±1.30* |
|
芪风中组 |
3 |
4.80±0.90* |
|
芪风低组 |
3 |
5.50±1.90 |
|
泛福舒组 |
3 |
6.10±3.20 |
|
模型组 |
3 |
16.10±6.80 |
免疫组织化学法观察芪风固表颗粒对肺组织Pannexin1,P2RX7蛋白表达的影响
在40倍视野下观察各组肺组织染色情况,模型组细胞颜色深且面积大,蛋白表达量较高。
空白组和芪风固表组较模型组着色稍浅,面积较小。
采用IOD/Area比值结果显示,芪风固表高、中、低剂量组及泛福舒胶囊组与模型组相比Pannexin1表达均降低(P<0.05,P<0.01);芪风固表各给药组与泛福舒组比较Pannexin1蛋白表达无明显差异。
结果显示,与模型组相比,芪风固表高剂量组、泛福舒胶囊组P2RX7表达降低(P<0.05,P<0.01);芪风固表各给药组与泛福舒组比较无明显差异。
与空白组比较,模型组 Pannexin1、P2RX7、Caspase-11蛋白表达显著升高;芪风固表高剂量组 Pannexin1、P2RX7、Caspase-11蛋白表达明显减少(P<0.05),中剂量组P2RX7蛋白表达减少(P<0.05);芪风固表给药组与泛福舒组比较蛋白表达无明显差异。
与模型组相比,空白组Pannexin1、P2RX7、Caspase-11 mRNA表达较低(P<0.05);与模型组相比,芪风固表高、中剂量组Pannexin1、Caspase-11 、P2RX7 mRNA明显减少(P<0.05),低剂量组Caspase-11 mRNA显著降低(P<0.05)。
与泛福舒组相比,芪风固表高剂量组Pannexin1、Caspase-11 mRNA降低(P<0.01),芪风固表中剂量组、低剂量组Caspase-11 mRNA降低(P<0.05)。

|
分组 |
Pannexin 1 |
P2RX7 |
Caspase11 |
|
芪风高组 |
1.57±0.21*△△ |
1.30±0.40* |
1.61±0.76*△ |
|
芪风中组 |
1.76±0.85* |
1.58±0.49* |
1.62±0.47*△ |
|
芪风低组 |
4.00±1.44 |
2.01±0.32 |
2.05±0.11*△ |
|
泛福舒组 |
2.82±0.73 |
2.20±0.68 |
3.38±0.38 |
|
模型组 |
5.93±1.84 |
3.09±0.69 |
4.29±1.08 |
|
空白组 |
1.02±0.27* |
1.04±0.36* |
1.00±0.11** |

芪风固表颗粒由经典名方生脉饮和玉屏风散加减而成,处方中黄芪外可固表止汗,内可补气升阳,白术健脾利水。
刺五加可健脾补肾,活血通络;防风可祛内外之风邪;麦门冬甘寒养阴生津,黄芪与麦冬配伍,使益气养阴之功更加显著,五味子酸温,敛肺生津止渴,六药合用,使方中有润有敛,有补有散,使气复津生,汗止阴存,诸症乃平,适于体质虚弱患者长期服用。
药理学研究表明,芪风固表颗粒可扶助正气,减少肺部炎症发作次数,减轻发作症状,从而达到祛除病邪、预防慢性肺系疾病的目的,其作用机制仍需进一步研究。

本实验通过HE染色观察肺组织结构变化,芪风固表颗粒可明显改善小鼠肺组织炎性细胞浸润和血管充血状态;从支气管、肺泡、血管和病变面积四个方面观察,芪风固表组小鼠整体病变程度均轻于模型组,能有效改善小鼠肺炎克雷伯菌感染后肺部病理损伤。
芪风固表组小鼠肺泡灌洗液内白细胞数明显低于模型组;肺组织细菌含量较模型组明显减少。
芪风固表颗粒能明显降低肺组织中的炎症反应,减少Kp在肺部的黏附。
研究表明Caspase-11的激活能够导致细胞焦亡,细胞焦亡作为一种新发现的炎症相关的细胞死亡方式,与肺部炎症疾病息息相关。
Caspase-11引导的焦亡通路在机体应对胞内脂多糖(LPS)的侵染中起重要作用。
LPS是肺炎克雷伯菌的主要致病成分,可刺激机体启动免疫系统,导致炎症反应。
LPS诱导Caspase-11依赖的Pannexin1通道的分裂和ATP的释放,进而激活嘌呤能P2X7受体,使细胞发生焦亡,Pannexin1对于ATP激活是必不可少的。
细胞外ATP浓度增高可以作为一种炎症信号,而Pannexin 1是释放P2RX7信号的通道,P2RX7的激活通常被认为是促炎症反应的中介,也与其他促炎细胞因子的释放有关。

本实验通过免疫组化、蛋白免疫印迹和Real-Time PCR实验证实芪风固表颗粒可以通过抑制肺组织中Pannexin1、P2RX7、Caspase-11蛋白及mRNA的表达,降低Kp感染后Caspase-11介导的细胞焦亡,从而预防和减轻肺炎克雷伯菌导致的肺部炎症反应的发生与发展。
综上所述,芪风固表颗粒能够对肺炎克雷伯菌感染引起的肺部炎性改变及损伤有明显的改善作用,其作用机制可能与抑制Caspase-11细胞焦亡信号通路有关。
该研究为芪风固表颗粒预防肺炎克雷伯菌感染提供新思路。